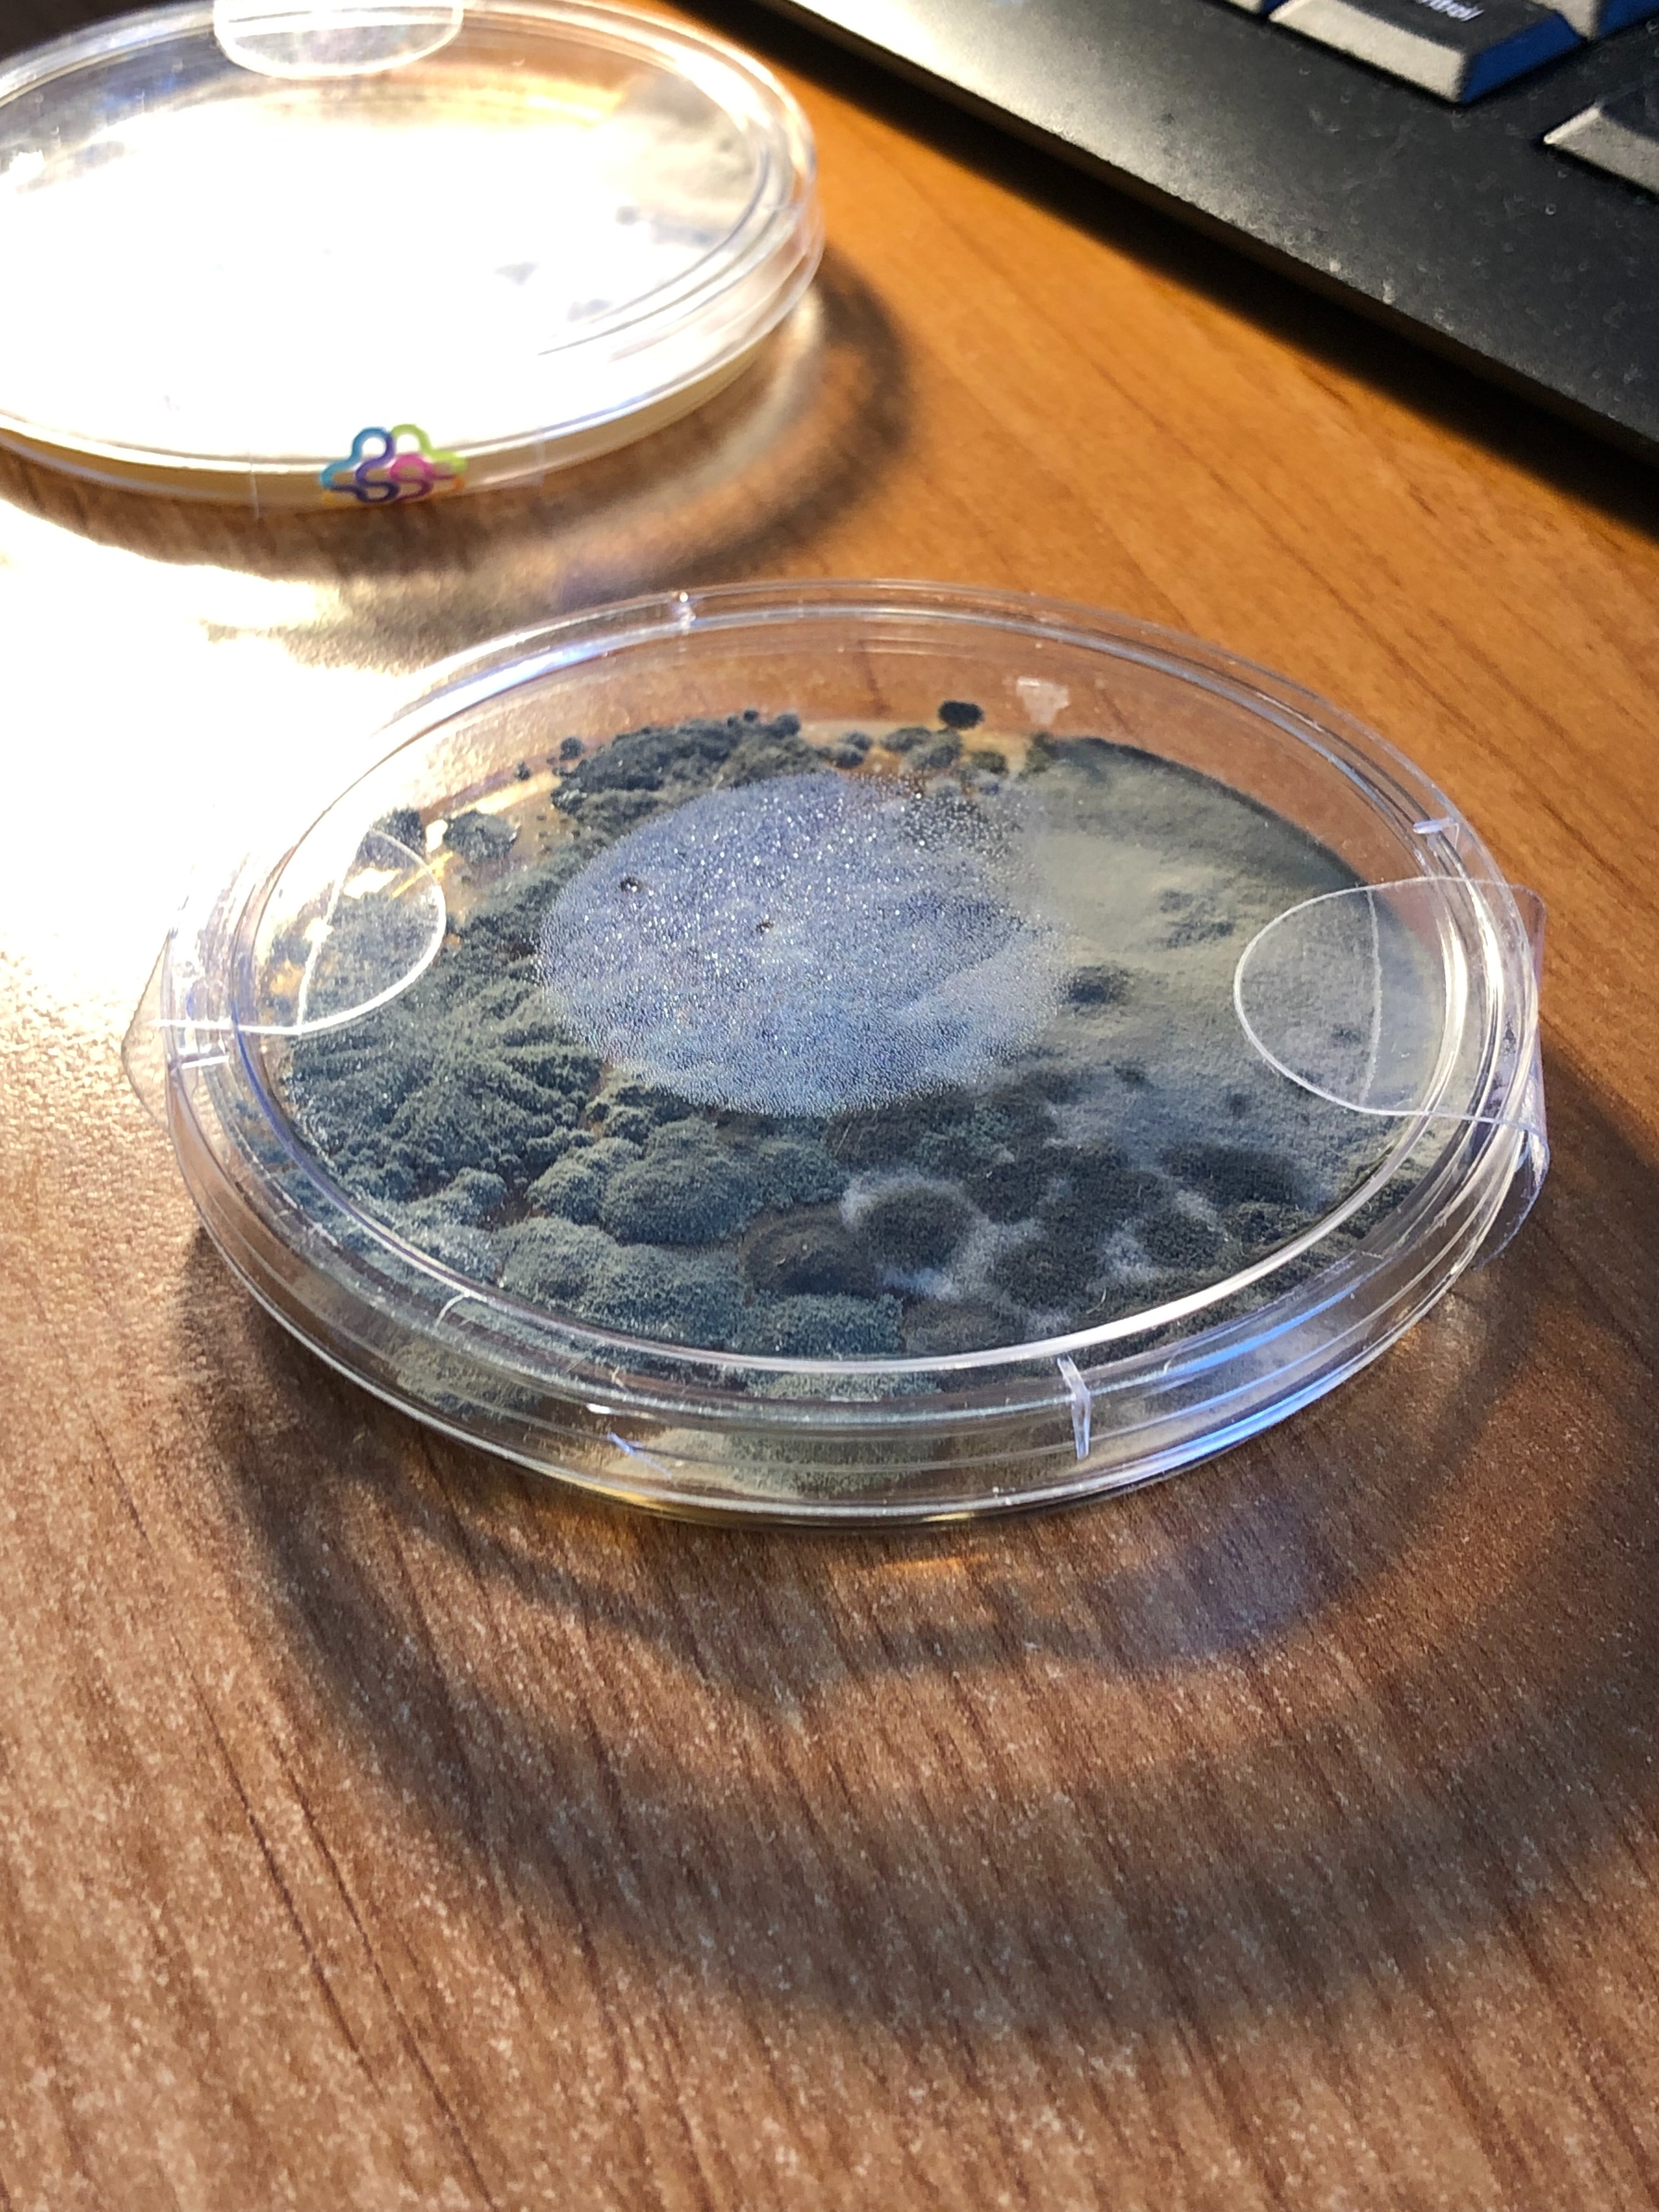

Waarom ik jouw hulp nodig heb
We kampen in Nederland steeds vaker met vochtproblemen, schimmelgroei en waterschade – door het veranderende klimaat, overstromingen, slecht geïsoleerde huizen en verouderde bouw. En toch is er bijna niemand in Nederland met internationale certificering om dit professioneel aan te pakken.
Daar wil ik verandering in brengen.
Ik ben vastbesloten om mij of iemand anders, te specialiseren via de IICRC (Institute of Inspection, Cleaning and Restoration Certification) – de wereldwijde autoriteit op het gebied van:
Waterschadeherstel (S500 / WRT)
Schimmelverwijdering en sanering (S520 / AMRT)
Deze certificeringen worden internationaal erkend en zijn dé standaard in onder andere de VS en Canada. In Nederland bestaan er nauwelijks opleidingen op dit niveau, dus ik moet ze online en internationaal volgen, wat het totaalbedrag behoorlijk verhoogt.
Wat het kost
De totale kosten voor de twee opleidingen, examens en officiële standaarden liggen tussen de $2.500 – $2.800 (ongeveer €2.600 – €2.900, afhankelijk van de wisselkoers). Hier zit in:
✅ IICRC WRT (Water Damage Restoration Technician) opleiding
✅ IICRC AMRT (Applied Microbial Remediation Technician) opleiding
✅ Examengelden per onderdeel
✅ Toegang tot officiële IICRC-standaarden (S500 & S520)
✅ Jaarabonnement op IICRC-normen
✅ Studieboeken & tools
Wat ik hiermee wil bereiken
Met deze kennis kan ik:
Professioneel woningen inspecteren, saneren en adviseren bij waterschade of schimmel
In Nederland een zeldzame maar essentiële dienst aanbieden
Lokale projecten of bewoners ondersteunen die met gezondheidsrisico’s kampen
Kennis delen met vakmensen, gemeenten en bewoners
Mijn missie: bijdragen aan een gezonder en veiliger Nederland – woning voor woning.
Hoe jij helpt
Met jouw donatie – groot of klein – help je mij om deze essentiële opleiding te volgen. In ruil daarvoor:
Deel ik graag mijn kennis via blogs, workshops of gratis advies
Help ik kosteloos mee aan lokale projecten waar het écht nodig is
Geef ik volledige transparantie over hoe het geld wordt besteed
Wil jij bijdragen aan een gezondere leefomgeving voor iedereen? Help mij deze unieke stap zetten.
Dank je wel
Ruud van der Meer
[email redacted]